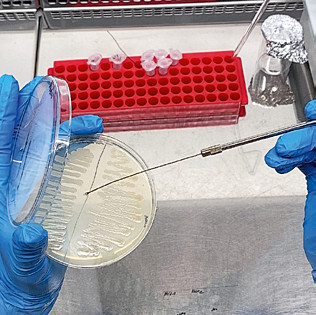

Протеин на метанотрофах
Каковы перспективы появления в России промышленного производства гаприна

До недавнего времени о глубокой переработке газа в стране никто не задумывался, а использование большой доли импортных компонентов в кормах считалось нормой. Введение санкций, усложнение торговых операций стали дополнительными факторами в пользу развития биотехнологий для создания альтернативных белковых кормовых продуктов. Один из способов базируется на культивировании бактерий, потребляющих метан. Гаприн, получаемый на выходе, уже известный рынку продукт еще со времен СССР. Возрождать технологию компании-энтузиасты начали с 2010-х годов. Эксперименты и исследования активно ведутся, и промышленное производство может появиться на горизонте уже ближайших нескольких лет.
В августе в Кирово-Чепецке Кировской области была открыта очередная опытно-промышленная установка по производству кормового белка из природного газа. Технология производства белка разработана компанией «Биопрактика» (резидент «Сколково»), соучредителем которой является негосударственный институт развития «Иннопрактика». В ходе реализации проекта были использованы инновационные решения, улучшающие процесс производства и качество конечного продукта. Особый акцент был сделан на инженерные разработки оборудования для синтеза белка, говорилось в сообщении «Иннопрактики». «Технология имеет большое значение, поскольку может стать одной из составляющих продовольственной безопасности страны», — отмечала компания. Кроме того, микробный белок обладает значительным экспортным потенциалом, особенно в Азиатско-Тихоокеанском регионе. Первые контракты на поставки опытных партий уже подписаны c российскими и китайскими партнерами, утверждает «Иннопрактика».
Проектная мощность опытно-промышленного производства составляет 250–300 т в год, уточняет заместитель гендиректора по науке «Биопрактики» Анастасия Червинская. По состоянию на середину сентября оно находилось на заключительном этапе пусконаладки. «Прежде всего данная установка решает задачу проверки масштабирования технологии и производства достаточного количества продукта для промышленных испытаний, — поясняет замруководителя. — Следующий шаг — это промышленный завод мощностью 20 тыс. т в год».
Фаза испытаний
Это не первый проект получения протеина из газа. В стране запущены и другие производства. Еще в 2018 году в Ивангороде Ленинградской области комбинат полного цикла по выпуску кормового протеина из бактерий, потребляющих природный газ, мощностью 6 тыс. т с перспективой расширения до 20 тыс. т открыл «Протелюкс». Инвестиции в проект составили около 2,5 млрд руб. Компания заявляла о намерениях возвести в течение ближайшего десятилетия 10 подобных заводов. На тот момент 100 % долей в ООО «Протелюкс» владел зарегистрированный на Кипре «Стафилис холдинг лимитед».
В 2021 году Stafilies подписал соглашение о стратегическом партнерстве с ведущим разработчиком технологии получения кормового белка из природного газа — компанией Unibio (Дания) для дальнейшего развития промышленного производства биопротеина под маркой Uniprotein на российском предприятии. По условиям лицензии с Unibio в России планировалось, что «Протелюкс» может производить до 1 млн т кормового белка в год. Однако с тех пор информации о проекте в открытых источниках не появлялось. Действует ли сейчас предприятие, сказать трудно: эксперты такой информацией не владеют, а с самим производителем связаться не удалось.
НТПК «Метаника» реализует подобный проект в Севастополе. Компания провела исследования по подбору и выращиванию штаммов, испытания на соответствие их параметров, сред и технологии процессов на метане. Зарегистрировала торговые марки «Метаприн» и Metaprin. Концепция проекта предполагает строительство завода по производству технологических заводских установок переработки метана природного газа и модульных мобильных комплексов его переработки, говорится на сайте компании.
«Гипробиосинтез» занимается возрождением, развитием и оптимизацией технологии получения микробного белка из метана и вовсе с 2015 года. Первые годы компания посвятила селекционированию собственного штамма-продуцента и его спутников, их исследованию, регистрации и паспортизации в одном из институтов Роспотребнадзора, чтобы доказать, что эти микроорганизмы безопасны, безвредны и могут полноценно применяться в кормах для животных. «Затем мы начали активную фазу деятельности, когда у нас пошли первые исследовательские партии гаприна, — рассказывает гендиректор «Гипробиосинтеза» Павел Нюньков. — Мы нарабатывали их с целью проведения полноценного анализа использования данного вида белка в аквакультуре, а также в кормлении птицы и поросят». С 2016 по 2019 год компания инициировала более десяти различных исследований, каждое из которых длилось от трех-четырех до семи-восьми месяцев. А в 2020 году «Гипробиосинтез» первым в стране получил регистрацию кормовой добавки на основе микробного белка для балансирования и обогащения рационов рыбы и сельхозживотных в Россельхознадзоре под брендом Dreamfeed.
Тогда же компания начала масштабирование технологии и закупила оборудование, на котором можно выпускать большие партии для последующих исследований. «Мы отдавали их на пробу научным институтам, коммерческим хозяйствам, которые проявляли интерес к нашему продукту и использовали его в рецептуре кормов», — говорит Нюньков. Он подчеркивает, что «Гипробиосинтез» видит в этой технологии большой коммерческий потенциал. Хотя она очень наукоемкая и затратная — как в финансовом плане, так и во временно́м.
Из других отечественных игроков технологией интересовался «Газпром», а «Татнефть» даже создала «дочку» для производства метанового белка — ООО «ТН-Биопротеин». Подобные планы (стоимостью 20 млрд руб.) были и у «Фининвеста» совместно с «Малой нефтехимической и биохимической компанией» (Республика Башкортостан), знает гендиректор аналитического агентства «ИМИТ» Любовь Савкина.
Особенности технологии у каждого свои
Гаприн — это белковая масса, полученная из инактивированных непатогенных метанокисляющих бактерий, объясняет генеральный партнер ГК «Биржа рационов» Дмитрий Калашников. «Процесс производства представляет собой высококачественную ферментативную технологию. Как и любое биотехнологическое направление, это сложное производство требует передовых решений в науке, энергетике, промышленности, методов хранения больших баз данных, необходима также целая плеяда специалистов, — перечисляет он. — Но я уверен, что только в нашей стране может быть реализован подобный проект промышленного масштаба, особенно с учетом того, что уже было сделано в ХХ веке нашими учеными, промышленниками, инженерами».
Переработка природного газа метанотрофными бактериями позволяет в итоге получать некий белковый концентрат, рассказывает Савкина. При этом существуют разные технологические подходы в зависимости от типа используемого биореактора. «Бактерии содержатся в определенных условиях, при определенной температуре, с учетом pH и концентрации питательных веществ, — знает она. — Затем эти бактерии проходят процесс подготовки к сушке (концентрация, сепарация, инактивация), после чего их можно использовать в качестве кормовой добавки в кормах для рыб и сельхозживотных».
Технология базируется на культивировании метанотрофов — бактерий, потребляющих метан — в специальных биореакторах высокого массообмена, говорит Червинская. Далее идет процесс отделения жидкости из готовой биомассы с помощью сепаратора и инактивация концентрата бактерий в пастеризаторе. На заключительном этапе концентрат сушат до готовой формы продукта в виде порошка или гранул.

Чтобы получить один килограмм бактерий в биореакторе, необходимо 1,3 кг (или примерно 2 м3) метана, подсчитал Центр промышленных инноваций «Газпром нефти». Обычно для этого подходит природный газ с содержанием метана 96 %. Чем чище «корм» для бактерий, тем лучше и стабильнее идет процесс, так как не образуется ненужных побочных продуктов. По оценке «Гипробиосинтеза», заводу мощностью 20 тыс. т готового продукта потребуется максимум 80 млн м3 природного газа. «Это совсем смешные показатели для нашей страны», — считает Нюньков.
Хотя каждая компания, реализующая проект по выпуску гаприна, имеет свои особенности в технологии, объединяет существующие проекты то, что ни один из них пока не вырос до промышленного производства, обращает внимание руководитель. «Сократить этот путь — создание технологии, эксперименты, исследования — вряд ли у кого-то получится, но кто раньше начал, тот быстрее выйдет на рынок с товарной продукцией», — отмечает он. Сам «Гипробиосинтез» уже близок к запуску первого завода, его строительство планируется завершить в самое ближайшее время. Так что уже вскоре у компании появятся первые промышленные партии продукции.
Пока же все выпускаемые партии исследовательские. Хотя установка компании, по словам руководителя, «достаточно мощная». «Мы можем делать до 100 т кормовой добавки Dreemfeed в год», — уточняет Нюньков. Сейчас установка используется компанией не только непосредственно для производства гаприна, а в первую очередь для отработки режимов безопасности, управления, контрольных измерений параметров, скорости вывода на рабочие режимы и так далее.